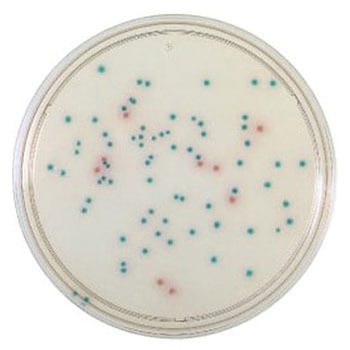

BD BBL TM CHROMagar TM サルモネラ寒天培地 100枚
CHROMagar(TM) サルモネラ寒天培地は、臨床材料・保菌者検査材料および食品検査材料などからサルモネラ菌を検出するための新しい選択分離培地です
タイプサルモネラ用種類寒天培地アズワン品番63-6527-67保管環境冷蔵内容量1個(100枚×1本)
注意
※個人宅(戸建住宅・集合住宅)様への配送は行っておりません。特別運賃
| 地域 | 単位 | 配送費 |
|---|---|---|
| 全国 | 数量1につき | ¥500/税込¥550 |
| 北海道地方 | 数量1につき | ¥500/税込¥550 |
| 沖縄地方 | 数量1につき | ¥500/税込¥550 |
| 離島 | 数量1につき | ¥20,000/税込¥22,000 |
バイオ・食品(菌)関連用品 の新着商品
カテゴリ



商品レビュー
よくあるご質問(FAQ)
- 質問:
- 製品の安全データシート(SDS)や有害物質使用制限に関するデータ(RoHS)等の書面が必要ですがどうすれば良いですか。
- 回答:
- お手数ですが下記URLのお問合せフォームよりご依頼ください。
お問合せ種類 *必須の中から必要な書類をお選びご依頼ください。
https://help.monotaro.com/app/ask
書類名)
1:SDS(MSDS)
2:RoHS(2)
3:非該当証明書
4:ChemSHERPA
5:その他(ミルシート・出荷証明書)
2022-04-07